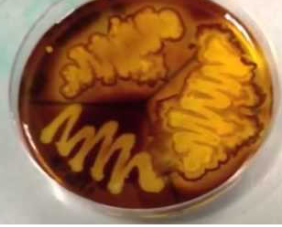
<p>clear zone around growth when reagent added</p>
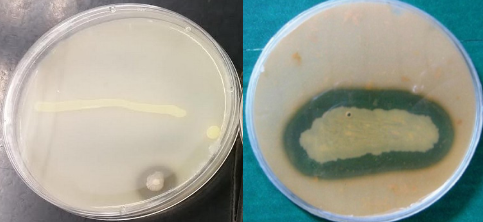
<p>clear zone around growth</p>
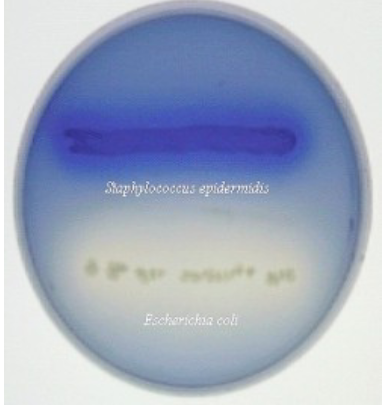
<p>blue and clearing of fat droplets around growth</p>

1/65
Looks like no tags are added yet.
Name | Mastery | Learn | Test | Matching | Spaced | Call with Kai |
|---|
No analytics yet
Send a link to your students to track their progress
sugar fermentation medium
Phenol red “sugar” broth
sugar fermentation control
Escherichia coli
sugar fermentation appearance
yellow broth → acid: bubble in tube → gas

mixed acid fermentation AKA
methyl red (MR)
mixed acid fermentation medium
MR-VP
mixed acid fermentation enzyme
formic hydrogenylase
mixed acid fermentation control
Escherichia coli
mixed acid fermentation appearance
red when reagent is added

mixed acid fermentation reagent
methyl red
Butanediol fermentation AKA
Voges-Proskauer (VP)
Butanediol fermentation medium
MR-VP
butanediol fermentation control
Enterobacter aerogenes
Butanediol fermentation appearance
red when reagent is added

butanediol fermentation reagent
Barritt’s reagents A&B
catalase production medium
nutrient agar
catalase production enzyme
catalase
catalase production control
Staphylococcus aureus
catalase appearance
bubbles when reagent added

catalse reagent
H2O2 - hydrogen peroxide
oxidase production medium
TSA agar or similar
oxidase enzyme
oxidase
oxidase control
Pseudomonas aeruginosa
oxidase appearance
dark purple spot when reagent added

oxidase reagent
oxidase test reagent
nitrate reduction medium
nitrate broth
nitrate reduction enzyme
nitratase
nitrate reduction control
Escherichia coli
nitrate reduction appearance
red when reagent added

nitrate reduction reagents
nitrate reagents A&B
starch hydrolysis medium
starch agar
starch hydrolysis enzyme
amylase
starch hydrolysis control
Bacillus subtilis
starch hydrolysis appearance
clear zone around growth when reagent added
starch hydrolysis reagent
iodine solution (Gram’s)
casein hydrolysis medium
skim milk agar
casein hydrolysis enzyme
caseinase
casein hydrolysis control
Bacillus subtilis
casein hydrolysis appearance
clear zone around growth
lipid hydrolysis medium
spirit blue agar
lipid hydrolysis enzyme
lipase
lipid hydrolysis control
Staphylococcus aureus
lipid hydrolysis appearance
blue and clearing of fat droplets around growth
tryptophan hydrolysis AKA
indole test
tryptophan hydrolysis medium
tryptose broth (or SIM medium)
tryptophan hydrolysis enzyme
tryptophanase
tryptophan hydrolysis control
Escherichia coli
tryptophan hydrolysis appearance
red layer floating on top when reagent is added

tryptophan hydrolysis reagent
Kovac’s reagent
urea hydrolysis medium
urea broth
urea hydrolysis enzyme
urease
urea hydrolysis control
Proteus vulgaris
urea hydrolysis appearance
fuschia, hot pink

H2S production medium
SIM medium
H2S production enzyme
cysteine desulfurase
H2S control
Proteus vulgaris
H2S appearance
black precipitate

citrate utilization medium
Simmon’s citrate agar slant
citrate utilization enzyme
citratase
citrate utilization control
Enterobacter aerogenes
citrate utilization appearance
growth and blue

phenylalanine deamination medium
phenylalanine agar slant
phenylalanine deamination enzyme
phenylalanase
phenylalanine deamination control
Proteus vulgaris
phenylalanine deamination appearance
green slant when reagent added

phenylalanine deamination reagent
10% ferric chloride
IMViC
I= indole, M=methyl red, V(i)=Voges-Proskauer, C=citrate utilization